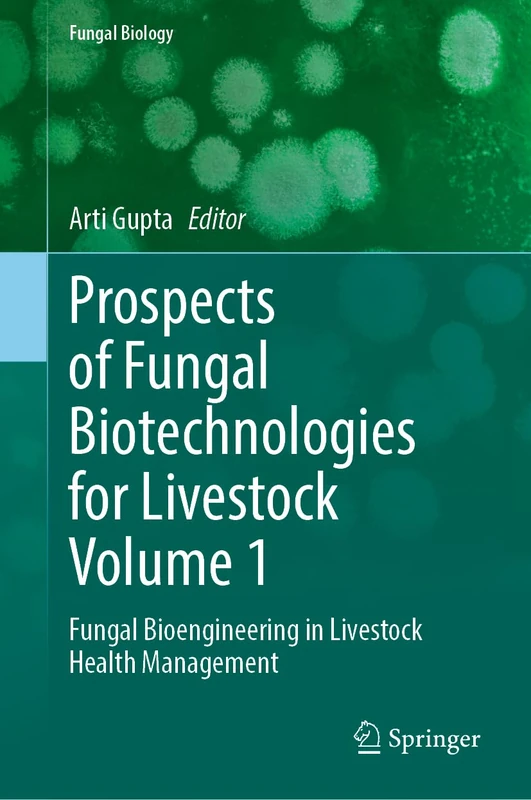
Springer - Fungal Bioengineering in Livestock Health Management

We can't find the internet
Attempting to reconnect
Something went wrong!
Hang in there while we get back on track

£163.35
Springer Prospects of Fungal Biotechnologies for Livestock Volume 2: Fungal Biotechnologies for Animal Cell Lines (Fungal Biology)
Price data last checked 138 day(s) ago - refreshing...
We'll watch every seller, every day. One email when your price arrives.
It has never been this cheap. We have no record of a lower price.
£163 today · cheaper than every other day in the last 9 months
NEW HERE?
Amazon shows you one price. We show you all of them.
Tosheroon watches Amazon prices so you don't have to. Every product on Amazon has a price history — we make it visible. Set the price you'd actually pay, and we'll email you the second it gets there. No app, no account, one email.
WHAT'S ON THIS PAGE
when this has been cheap or pricey
where the price is heading next
all-time high & low, recent range
name your number, we'll email you
Price History & Forecast
Grey patches = out of stock. Cheaper = lower on the chart. Hover for exact prices.
Last 141 days • 141 data points (No recent data available)
Price Distribution
Price distribution over 141 days • 2 price levels
Price Analysis
Most common price: £180 (96 days, 68.1%)
Price range: £163 - £180
Price levels: 2 different prices over 141 days
Product Specifications
- Brand
- Springer
- Format
- hardcover
- ASIN
- 3032064775
- Domain
- Amazon UK
- Release Date
- 23 November 2025
- Listed Since
- 15 August 2025
Barcode
No barcode data available
Similar Products You Might Like
Springer - Fungal Bioengineering in Livestock Health Management
Springer

Industrially Important Fungi for Sustainable Development: Volume 2: Bioprospecting for Biomolecules (Fungal Biology)
Springer

Springer Industrially Important Fungi Volume 1 - Fungal Biology
Springer

Fungal Additives and Bioactives in Food Processing Industries: Challenges and Prospects (Fungal Biology)
Springer

Fungal Biopolymers and Biocomposites: Prospects and Avenues
Springer

Bioprospecting of Multi-tasking Fungi for a Sustainable Environment: Volume I
Springer

Fungal Biopolymers and Biocomposites: Prospects and Avenues
Springer

Fungal Waste Biomass Management for Energy, Environment and Value-Added Products (Fungal Biology)
Springer

Bioprospecting of Multi-tasking Fungi for a Sustainable Environment: Volume I: 1
Springer

Biology of the Fungal Cell: 8 (The Mycota, 8)
Springer

Biology of the Fungal Cell: 8 (The Mycota, 8)
Springer

Fungal Resources for Sustainable Economy: Current Status and Future Perspectives
Springer

Molecular Mechanisms in Host - Fungal Interactions (Fungal Biology)
Springer

Springer - Progress in Mycology: Biology and Biotechnology
Springer

Progress in Mycology: Biology and Biotechnological Applications
Springer

Springer - Emerging and Epizootic Fungal Infections in Animals
Springer

Fungal diversity, ecology and control management (Fungal Biology)
Springer

Fungal Machines: Sensing and Computing with Fungi: 47 (Emergence, Complexity and Computation, 47)
Springer

Fungal Biotechnology: Prospects and Avenues (Progress in Mycological Research)
CRC Press

Frontiers in Entomopathogenic Fungi: Diversity, Ecology and Bioprospects
Springer

Academic Press - Biodiversity, Bioengineering, and Biotechnology of Fungi
Academic Press
Academic Press: Advanced and Sustainable Biotechnologies from Fungi
Academic Press

Biotechnology of Yeasts and Filamentous Fungi (Grand Challenges in Biology and Biotechnology)
Springer

Recent Advances in Human Fungal Diseases: Progress and Prospects
Springer